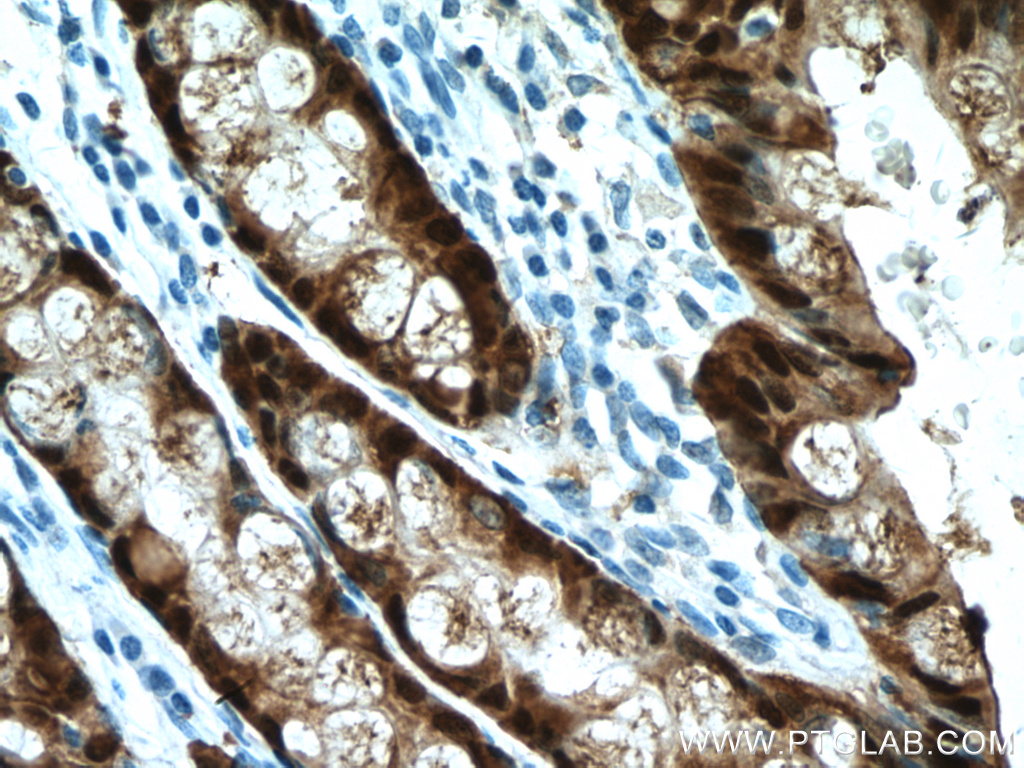

验证数据展示
产品信息
66686-1-PBS targets Galectin-4 in WB, IHC, IF-P, Indirect ELISA applications and shows reactivity with human samples.
| 经测试应用 | WB, IHC, IF-P, Indirect ELISA Application Description |
| 经测试反应性 | human |
| 免疫原 |
CatNo: Ag4049 Product name: Recombinant human LGALS4,GAL4 protein Source: e coli.-derived, PGEX-4T Tag: GST Domain: 1-323 aa of BC034750 Sequence: MAYVPAPGYQPTYNPTLPYYQPIPGGLNVGMSVYIQGVASEHMKRFFVNFVVGQDPGSDVAFHFNPRFDGWDKVVFNTLQGGKWGSEERKRSMPFKKGAAFELVFIVLAEHYKVVVNGNPFYEYGHRLPLQMVTHLQVDGDLQLQSINFIGGQPLRPQGPPMMPPYPGPGHCHQQLNSLPTMEGPPTFNPPVPYFGRLQGGLTARRTIIIKGYVPPTGKSFAINFKVGSSGDIALHINPRMGNGTVVRNSLLNGSWGSEEKKITHNPFGPGQFFDLSIRCGLDRFKVYANGQHLFDFAHRLSAFQRVDTLEIQGDVTLSYVQI 种属同源性预测 |
| 宿主/亚型 | Mouse / IgG2b |
| 抗体类别 | Monoclonal |
| 产品类型 | Antibody |
| 全称 | lectin, galactoside-binding, soluble, 4 |
| 别名 | 3C2G3, Antigen NY CO 27, Antigen NY-CO-27, Gal 4, GAL4 |
| 计算分子量 | 323 aa, 36 kDa |
| 观测分子量 | 36 kDa |
| GenBank蛋白编号 | BC034750 |
| 基因名称 | Galectin-4 |
| Gene ID (NCBI) | 3960 |
| RRID | AB_2882040 |
| 偶联类型 | Unconjugated |
| 形式 | Liquid |
| 纯化方式 | Protein A purification |
| UNIPROT ID | P56470 |
| 储存缓冲液 | PBS only, pH 7.3. |
| 储存条件 | Store at -80°C. The product is shipped with ice packs. Upon receipt, store it immediately at -80°C |
背景介绍
Galectins are a family of animal lectins defined by shared characteristic amino-acid sequences and affinity for β-galactose-containing oligosac-charides (PMID: 8063692). Galectin-4 contains two arbohydrate recognition domains (CRDs) and is expressed in the epithelium of oral mucosa, esophagus, and intestinal and colonic mucosa (PMID: 15546874; 15115909). Aberrant expression of galectin-4 has been reported in several cancers.